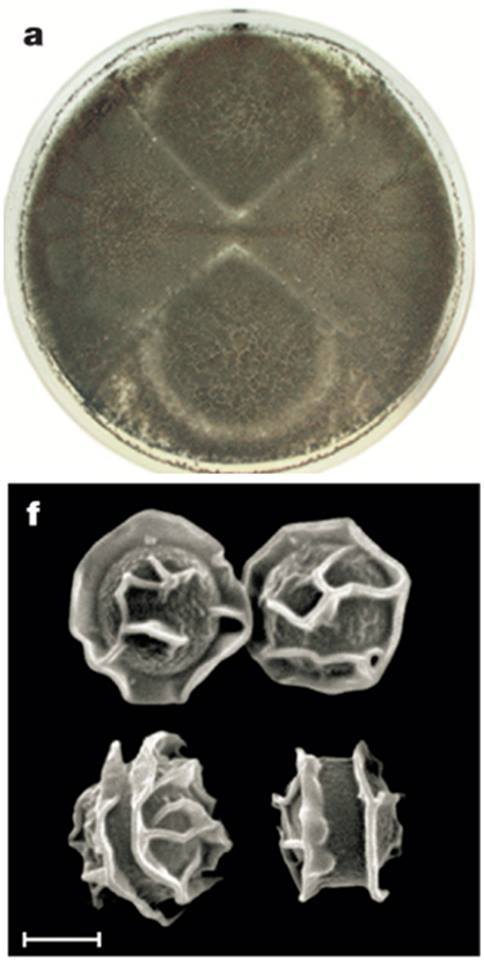
10-4.jpg

네이처와 미국곰팡이학회지(Nature vs. Mycol
곰팡이 이야기 10
같은 실험을 하고도 누구는 세계 정상의 과학 저널 네이처(Nature)에 논문을 게재하고 누구는 이름도 없는 잡지에 논문을 게재한다. 지난주에 이야기한 곰팡이기회감염증을 일으키는 연기아스페르길루스(Aspergillus fumigatus)에 대한 경험담을 소개하고자 한다.
곰팡이도 암수가 있다. 그리고 사랑도 한다. 필요에 따라 암수가 사랑을 해서 튼실한 알(포자)을 만들기도 하고 급하면 대충 스스로 포자를 만든다.
요즘처럼 온도와 습도가 높은 여름철은 곰팡이에게는 한철이다. 호시절에 최대한 자기 종족을 많이 퍼뜨려야 한다. 이 때는 암수가 사랑을 나눌 시간도 아깝다. 따라서 곰팡이는 그냥 자기 몸을 뚝뚝 잘라 포자를 만들어 사방에 뿌린다. 암수의 사랑 없이 급하게 만든 포자를 분생포자(分生胞子, conidium) 또는 무성포자(無性胞子)라고 한다.
호시절에 많은 분생포자를 만들어 세력 확장에는 성공했으나 찬바람이 불면 겨울 날 일이 걱정이다. 추위에도 버틸 튼실한 포자가 필요하다. 이 때에 곰팡이는 암수가 사랑을 하여 춥고 건조한 겨울을 버틸 튼실한 포자를 만든다. 이 포자를 암수가 만나서 만든 포자라고 하여 유성포자(有性胞子, sexual spore)라고 한다.
연기아스페르길루스(Aspergillus fumigatus)는 건초더미, 퇴비, 토양유기물에 살면서 식물찌꺼기를 분해하여 다시 흙으로 돌려보낸다. 이 곰팡이는 건초에서 미세먼지 크기의 수많은 포자를 만드는데 농부들이 건초 작업을 하면 포자가 연기처럼 날린다고 하여 연기(fumigatus) 아스페르길루스로 불린다. 워낙 많은 수의 무성포자를 만들고 열이 발생하는 환경에서 살기 때문인지 이 곰팡이는 암수가 사랑을 하여 만드는 유성포자는 만들지 않는 것으로 알려져 있다 .

<그림 1. Aspergillus fumigatus, KACC M2080, 위는 CYA 배지 배양 사진, 아래는 현미경 관찰 사진. 이 곰팡이는 과거에는 농업인들에게 폐질환을 주로 일으켰다. 하지만 지금은 면역이 저하된 사람들에게 치명적인 폐질환을 유발하는 대표적인 곰팡이기회감염증 유발 균이다. 저자의 미발표 사진>
나는 2002년부터 연기아스페르길루스와 유사종들의 분류연구를 수행하였다. 분류는 많은 개체들 중에서 같은 종족끼리 묶고 이름을 지어주는 학문이다. 잘 아시는 것처럼 암수가 만나 자연스럽게 사랑을 하고 자식을 만들면 이들은 같은 종족이다. 그런데 연기아스페르길루스와 같이 독신을 고집하는 생물은 같은 종족을 구분해내기가 어렵다.
연기아스페르길루스와 유사종 곰팡이를 우리나라를 포함하여 전 세계적으로 약 150균주를 모았다. 현미경 관찰과 유전자 검사를 통하여 같은 종족 후보를 모으고 눈높이에 맞게 짝을 지었다. 그리고는 신방을 차리고 좋은 먹이도 넣어 주고 불도 꺼 주었다. 빠른 곰팡이들은 2주가 되면, 보통 한달이 되면 유성세대 포자를 만드는데 연기아스페르길루스는 한달 반이 지나도 옥동자 소식이 없었다. 결국은 포기하고 유전자검사를 통하여 연기아스페르길루스를 다른 유사종과 구분하였다. 이 과정에서 세계에서 한번도 보고되지 않은 신종도 발견하고 세계 표준이 된 나름 우수한 분류 체계도 만들었다. 그 결과는 미국곰팡이학회지(Mycologia)에 논문으로 게재되었다.

<그림 2. Mycologia에 게재한 저자의 Aspergillus fumigatus 분류 논문, Mycologia는 미국균학회에서 발간하는 곰팡이 전문 저널이다.>
그런데 어느 날 내게는 그렇게도 독신을 고집하던 연기아스페르길루스가 옥동자를 낳았다는 소식을 들었다. 그것도 세계최고의 과학 저널 네이처(Nature)에서. Celine M. O'Gorman, Hubert T. Fuller, Paul S. Dyer. 2009. Discovery of a sexual cycle in the opportunistic fungal pathogen Aspergillus fumigatus (곰팡이 기회감염증을 유발하는 연기아스페르길루스의 유성세대 발견) Nature 457: 471-474.

<그림 3. Aspergillus fumigatus의 유성세대 발견을 다른 O'Gorman 박사님의 Nature 논문>
Nature는 과학자라면 한번쯤 논문을 실고 싶어 하는 세계 최고의 과학 저널이다.
나는 5년간 이 실험을 하였는데도 성공하지 못했는데 영국의 노팅험 대학의 O’Gorman 박사(여)는 무슨 특별한 방법이 있었을까? 단숨에 논문을 읽고는 허탈했다. 그녀도 나와 똑같은 방법을 사용했다.
차이는 기다리는 시간이었다. 나는 1달 반을 기다렸는데 그녀는 6개월을 기다렸다. 단순하게 보면 4개월반의 시간 차이지만 자세히 보면 기다리는 질 자체가 달랐다. 나는 회의를 그득 품은 기다림이었고 그녀는 확신에 찬 기다림이었다.

<그림 4. Aspergillus fumigatus의 완전세대 형성 및 유성포자 사진>
위는 A. fumigatus 암수를 대치 배양한 사진. 상하와 좌우가 각각 암수이다. 즉 위와 아래가 같은 균주이고 좌와 우가 같은 균주이며 서로 만나는 지점에서 유성세대 포자가 형성된다. 사선으로 그어진 곳에서 흰색의 점이 유성세대 포자. 아래는 유성세대 포자의 전자현미경 사진 . O'Gorman 박사님의 위의 Nature 논문 데이터 인용.
<그림 5. Aspergillus fenelliae의 유성세대 포자 형성 사진>
A. fenelliae는 A. fumigatus와 매우 가까운 종이다. 저자의 실험에서 A. fenelliae는 유성포자를 형성하였으나 A. fumigatus는 유성포자를 형성하지 않았다. 위사진의 상하는 KACC 41687 좌우는 KACC F3746 균주. 양 균주가 만나는 지점에 물방울이 보이고 그 안에 유성세대 포자 덩어리가 보인다. 아래 사진은 유성세대 포자의 전자현미경 사진, 위의 사진은 Mycobiology의 저자의 발표논문을 인용하였고 아래는 미발표 데이터
O’Gorman 박사는 곰팡이 분자유전학자다. 그녀는 곰팡이가 사랑을 나누는 메카니즘을 알고 있었고 연기아스페르길루스가 곰팡이 교배에 필요한 200개 이상의 유전자를 모두 가지고 있다는 것을 확인하였다. 또한 집단 유전학을 통하여 연기아스페르길루스의 암수의 성비가 1:1에 가깝고, 균형 성비를 유지할 만큼 최근까지 교배가 이루어져 왔음을 가정하였다. 이에 그녀는 모국 아일랜드에서 분리한 암컷 6균주, 수컷 6균주를 엄선하여 작정하고 짝짓기를 시도했다. 두달이 지나고 세달이 지나서도 유성세대 포자를 만들지 않았지만 이 분야의 해박한 기초지식은 그녀를 포기하지 않게 하였다. 결국 보통보다 4배 더 오래 시간인 6개월을 기다려 옥동자를 얻었다.
반면 나는 곰팡이 교배에 대하여 지식이 없었다. 그리고 암수를 구분하지도 않았다. 또한 이 곰팡이가 독신으로 알려져 있었으므로 유성포자에 대한 큰 기대도 하지 않았다. 절차상 의무방어로 이 실험을 했다. 따라서 의무방어 기간이 지나자 미련 없이 버렸다. 지금 생각해보면 한달 반이 지나고 현미경 관찰할 때에 한쌍의 조합에서 유성세대 포자의 전구체 같은 것을 관찰하였는데도 고민도 없이 오염으로 치부하고 버렸든 것 같다.
결국 공부다. 높은 산이 밑동지가 넓은 것처럼 기초가 튼튼해야 한다. 학자는 모름지기 늘 공부하고, 넓게 공부하고, 늘 새로운 지식을 받아들여야 한다. 유홍준 교수는 아는 만큼 보인다고 했다. 똑 같은 문화재를 봐도 지식에 따라 느끼는 차가 크다. 과학도 마찬가지다. 아는 만큼 결과를 내고, 아는 수준이 곧 논문 수준이다. 대과학자의 경구가 문득 생각난다. 기회는 준비된 사람에게 온다(Chance favors the prepared mind) (루이 파스퇴르).